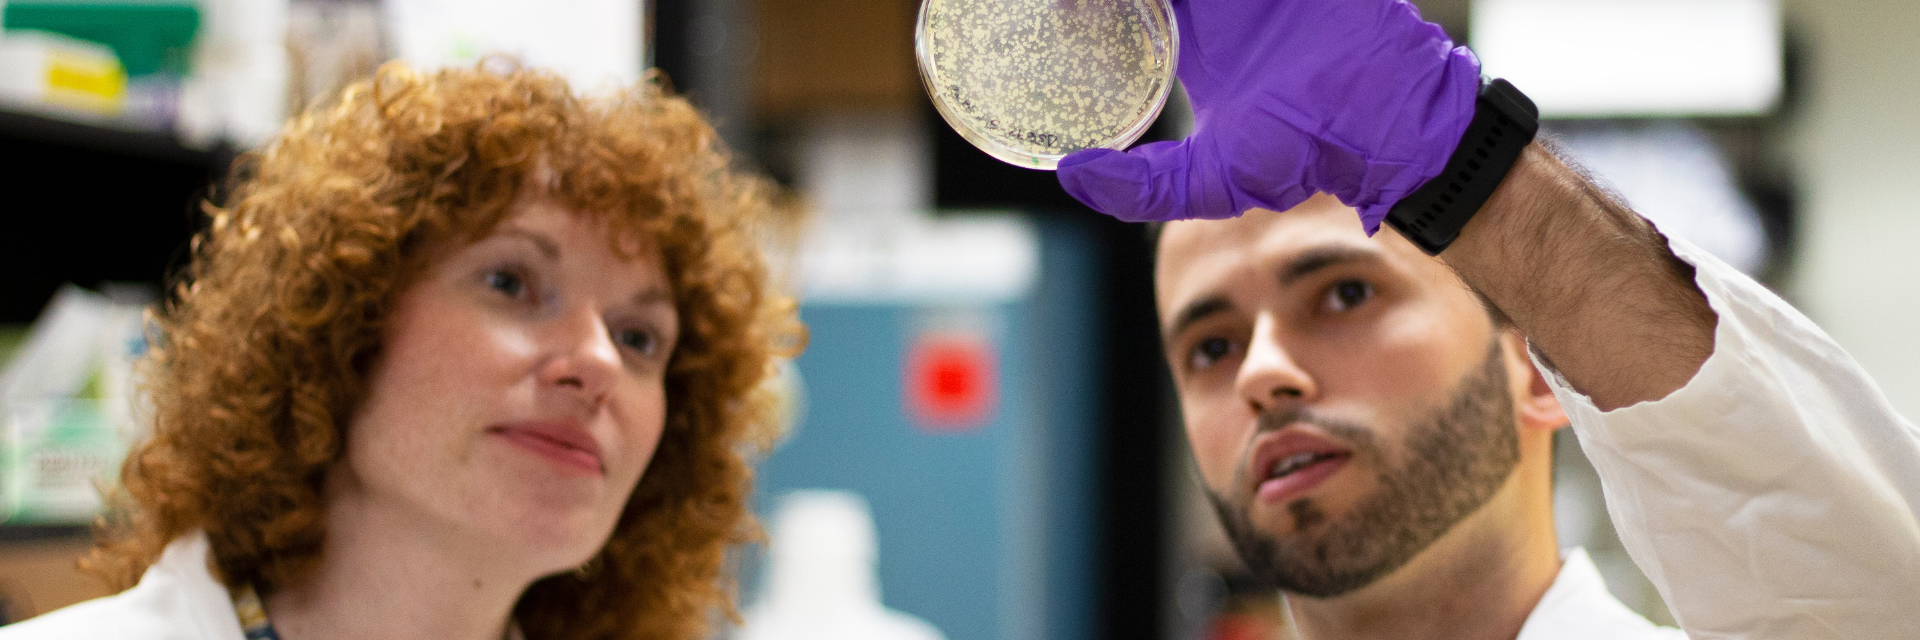
Image of Dr. Geddes-McAlister and PhD student in lab

PhD Molecular and Cellular Biology
Students in the PhD in Molecular and Cellular Biology program work alongside faculty in the pursuit of fundamental and applied research questions involving diverse biological systems (plants, humans and other animals, prokaryotic and eukaryotic microbes) at the molecular and cellular level.
Students work with leading experts in the fields of biochemistry, cell biology, immunology, microbiology, molecular biology and genetics, plant biology, neuroscience, and vaccinology and take advantage of state-of-the-art facilities for tissue culture, microscopy, genomics, nuclear magnetic resonance, and mass spectrometry.
Through this program, students develop into independent and creative scientists, ready to take on roles as scholars in academia or as leaders in industry or government.
Degree Details
The PhD in Molecular and Cellular Biology program is offered in five areas of study:
- Biochemistry
- Cell Biology
- Microbiology
- Molecular Biology and Genetics
- Plant Biology

Collaborative Specializations
PhD in Molecular and Cellular Biology students may also add a collaborative specialization in Toxicology, Neuroscience or One Health. A collaborative specialization is an intra-university graduate field of study that provides an additional multidisciplinary experience for students enrolled in and completing the degree requirements for an MCB graduate program.
Hear from PhD Molecular and Cellular Biology graduates

I research epigenetic regulation in cells, which if gone wrong creates many human diseases. It is important for us to understand how healthy cells maintain their epigenome so we can harness the knowledge to reprogram diseased cells. I also get to teach undergraduate students as a TA, and this is where I make the most direct impact. It is satisfying to know that I am contributing to the education and campus experience of students. I try to alleviate the fear of making mistakes in the lab, and generate enthusiasm for science and research.

The University of Guelph is a renowned university and, as a former graduate student at U of G, it helped me build myself for the future. The graduate courses offered in the Molecular and Cellular Biology department are high-calibre and prepare students really well for the outside world. Also, you get to meet and benefit from world-known scientists who have made tremendous contributions to their areas of research.

During my undergraduate degree at the University of Guelph, I was able to join the MCB department in my third year as a work study student. It was my first exposure to an academic research lab and since then, I never wanted to leave! The department is filled with amazing faculty and other students who create an amazing workspace for conducting research. My advisor, Dr. Jasmin Lalonde, was an excellent mentor. His expertise in neuroscience and molecular biology allowed me to continuously grow as a researcher. He was always available to help me troubleshoot my experiments and gave me advice and support. His excellent teaching skills helped me continue to mature into a successful researcher over the course of my graduate studies.

I've always been fascinated by the brain and this interest only intensified when I did my undergraduate research projects at Guelph. I knew that I wanted to pursue research in neuroscience, but wanted to be able to learn many techniques along the way. Luckily, I am able to do that in my PhD work. The sense of community and collaboration within my home department is palpable and everyone is always ready to help. I've developed many friendships with both professors and graduate students alike.
Choosing an Advisor
Check out Before You Apply for helpful advice on identifying and reaching out to faculty members.
- Review current graduate student opportunities in the Department of Molecular and Cellular Biology
- Visit our CBS ReSearch database to search by research topic.
- Visit the Graduate Calendar for a full list of faculty members who work with graduate students.

Degree Requirements
Students must complete MCB*7500 PhD Research Topics in Molecular and Cellular Biology. This two-semester course should be completed in the first year of study and normally within the first two semesters.
Students without an MSc degree in Molecular and Cellular Biology or the equivalent are required to take one additional graduate course. Other courses may be taken on the recommendation of the Advisory Committee.
An average of “B-minus” (70%) must be achieved in the prescribed courses.
To be a candidate for the PhD degree, each student must pass a PhD Qualifying Exam. The Qualifying Examination is completed before the end of the fifth semester (for students with an MSc) or the end of the seventh semester (for students without an MSc).
The PhD thesis research must involve original inquiry into a well-defined question in the molecular biosciences. It is expected to result in the publication of one or more papers in high-quality peer-reviewed journals. The research must represent a significant contribution to the relevant research field.
There are three pathways for admission to the PhD program:
- Students who have achieved an “A-minus” (80%) average or higher during the last two years of full-time study while completing a four-year honours BSc program (or its equivalent) and who provide evidence of research aptitude and potential based on laboratory research experience may apply to enter the PhD program directly.
- An MSc student may apply to transfer to the PhD program before completing the MSc degree. To be eligible for transfer, the student must have completed a high-quality undergraduate degree with a grade average of B+ or higher. Before applying for transfer to the PhD program, students must complete MCB*6500 (MSc Research Topics in Molecular and Cellular Biology), plus an additional course with at least 0.5 graduate course credit, attaining an overall A-minus average (at least 80%). Applications for transfer must be approved by the end of the fourth semester in the MSc program.
- Applicants may have completed a recognized master’s degree in a relevant discipline with a minimum academic standing of “A-minus” (80%).

Visit Us
Contact individual faculty members by email and/or telephone to arrange a visit. Be prepared to discuss your specific interest in their research program. To assist our faculty in making a selection from the pool of interested students, we suggest you include in your correspondence the following:
- Courses completed (plus the mark received)
- Relevant research and/or work experience you have, and with whom
- Whether you have a scholarship
- Two or three academic or research references
- Reason for contacting our particular faculty
Contact Us
Dr. Rebecca Shapiro
Graduate Program Coordinator
Email: shapiror@uoguelph.ca
Phone number: 519-824-4120 ext 53390
Jillian Cockwell
Graduate Program Assistant
Email: cbsmcb@uoguelph.ca
Phone number: 519-824-4120 ext. 56246
Karen White
Graduate Admissions Assistant
Email: cbsgrad@uoguelph.ca
Phone number: 519-824-4120 Ext. 52730